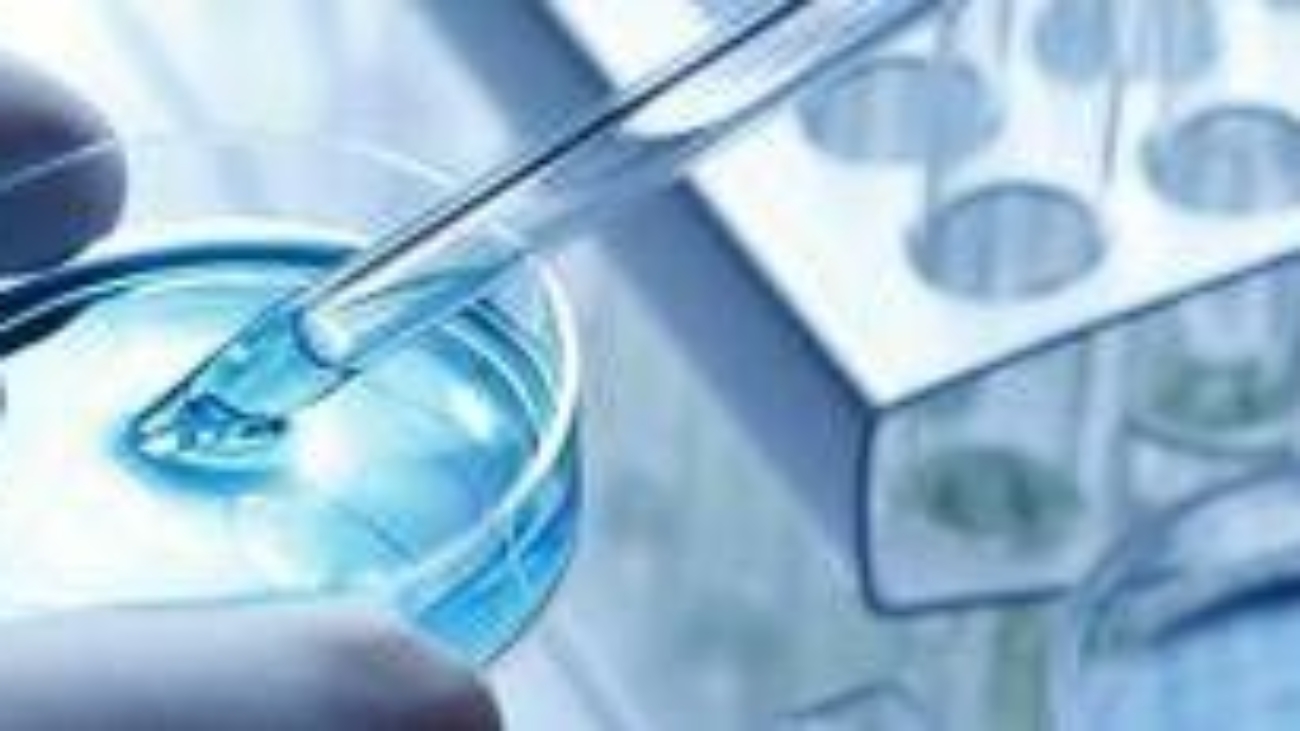
Infezioni multiresistenti, nuovi dati confermano efficacia cefiderocol

(Adnkronos) – Mastoplastica additiva operazione più richiesta in Italia, al secondo posto blefaroplastica mentre cala liposuzione per ‘fenomeno Ozempic’
Primo vaccino Rna per i gatti, efficace contro 5 infezioni
(Adnkronos) – Il vaccino tutela gli animali da 5 patogeni: 4 virus altamente contagiosi e un batterio
Notti in Pronto soccorso, vite in corsia. Medici e infermieri si raccontano nel podcast ‘Globuli bianchi’
(Adnkronos) – Lanciato dall’Asst Valle Olona: “E’ il primo interamente realizzato da un ospedale pubblico. Un viaggio dietro le quinte della sanità, obiettivo costruire un rapporto diretto con i cittadini”
Infezioni multiresistenti, nuovi dati confermano efficacia cefiderocol
(Adnkronos) – Presentati a congresso Escmid risultati trattamento contro Enterobacterales produttori di Mbl
Maniaci dell’ordine o disordinati cronici, cosa dice la psicologia
(Adnkronos) – “I primi amano il controllo, gli altri lo vivono come un’oppressione”. L’analisi di Annamaria Giannini dell’università La Sapienza di Roma
Allergie, non solo pollini nemici degli occhi: l’inquinamento aumenta fino a 9 volte il rischio di congiuntivite
(Adnkronos) – Gli oculisti dell’Aimo rilanciano i risultati di una revisione di 29 studi su oltre 3 milioni di visite: “Anche l’ambiente in cui viviamo e lavoriamo può influenzare in modo significativo la salute della superficie oculare”. Cinque consigli per proteggersi
Morte 13enne Alessandro Farina, legale famiglia ‘Cassazione conferma tardiva diagnosi diabete’
(Adnkronos) – ‘Sentenza pone fine a vicenda giudiziaria che ha interessato l’Ao di Salerno – Il caso ha ispirato la legge 130 del 2023’
Bozzetto (Mimesi): “Liste d’attesa e digitalizzazione i punti critici sui social”
(Adnkronos) – ‘Covid il vero spartiacque sull’attenzione alla salute, commenti online triplicati’
Sport e Salute, al via il contest ‘attiviamoci tutti i giorni in movimento’ per 2,3 milioni di studenti
(Adnkronos) – Mettere giù il telefono, alzarsi dalla sedia e muoversi. Sembra la normalità, ma per milioni di ragazzi non lo è: il drop out sportivo giovanile è uno dei fenomeni più preoccupanti. Sport e Salute raccoglie la sfida e, dopo aver coinvolto negli anni scorsi milioni di studenti sui temi dello sviluppo sostenibile e della corretta alimentazione, rilancia e ripropone un nuovo contest. È “Attiviamoci Tutti i giorni in Movimento” e chiamerà all’azione 12.700 scuole ed oltre 120.000 classi di scuola primaria e scuola secondaria di primo grado, già protagoniste di progetti “Scuola Attiva Kids” e “Scuola Attiva Junior”, per un totale di circa 2,3 milioni di alunni tra i 6 e i 13 anni.
Tumori ginecologici-mammari, problemi di sessualità per 40% pazienti ma solo 7% chiede aiuto
(Adnkronos) – In Italia ogni anno più di 71mila nuovi casi – Si apre oggi a Solomeo (Perugia) il congresso nazionale ‘Mi Amo Ancora’